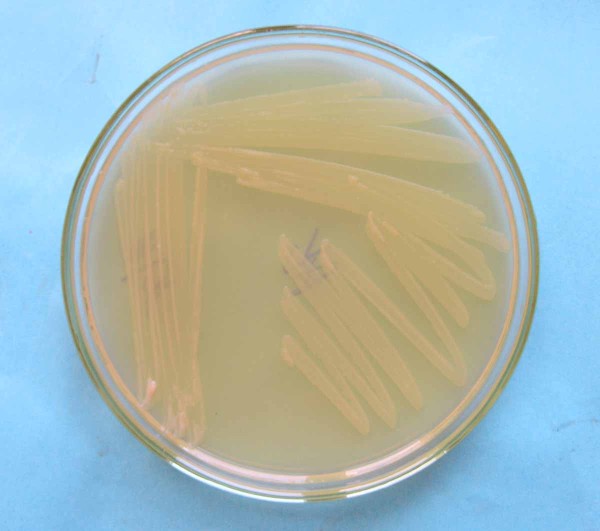
Kolonie bakteri&iacute; Rhizobium radiobacter

Choroby řepy: Bakteriální choroby řepy (I).
11. 10. 2021 Choroby Zobrazeno 383x
Bakteriální choroby se v porostu řepy cukrovky v ČR nevyskytují tak často jako houbové choroby, ale pokud nastanou vhodné podmínky pro růst a množení bakterií, mohou výrazně snížit výnos a cukernatost a posléze i skladovatelnost bulev.
Bakteriální listová skvrnitost řepy
Listové bakteriální choroby na řepě způsobují bakterie rodu Pseudomonas a Curtobacterium. Napadají nejen řepu cukrovku, ale i ostatní druhy rodu řepa a mangold. Bakterie rodu Pseudomonas, především Pseudomonas syringae pv. aptata, způsobují bakteriální listovou skvrnitost řepy. Na této chorobě se může podílet i další druh rodu Pseudomonas a to P. syringae pv. syringae, která má široký okruh hostitelů.
Příznaky napadení se zpočátku projevují na listech jako nepravidelné vodnaté skvrnky s tmavým lemem. Později se skvrny zbarvují šedohnědě a nekrotizují. Nekrotické pletivo může vypadávat a list vypadá jako potrhaný. Pokud bakterie pronikne do cévních svazků, můžeme její přítomnost pozorovat na listových žilkách nebo na příčném řezu kořene hnědnutím až zčernáním cévních svazků.
Bakterie Pseudomonas syringae jsou pohyblivé, aerobní a gramnegativní krátké tyčinky. Kolonie bakterií na agaru jsou hladké s celistvým okrajem, šedobílé až béžové barvy, na King B agaru tvoří difúzní zelený pigment. Optimální teplota pro růst a množení se pohybuje mezi 21–25 °C. Patogen proniká do rostlin přes průduchy a hydatody nebo přes poranění. V porostu řepy se během vegetace šíří odstřikujícími kapkami vody (větrný déšť). Při vysokém infekčním tlaku se snižuje asimilační plocha a může dojít ke ztrátám. Bakterie přežívá na posklizňových rostlinných zbytcích v půdě a na osivu.
Bakteriální stříbřitost řepy
Curtobacterium flaccumfaciens pv. beticola je původcem bakteriální stříbřitosti řepy.
Příznaky napadení se projevují stříbřitým vzhledem listů podél žilek, později epidermis (pokožka listu) praská a list má zdrsněný vzhled. Listy jsou zduřelé, tuhé, rostliny vadnou a odumírají.
Bakterie je grampozitivní, optimální teplota pro růst 24–27 °C, přežívá v posklizňových zbytcích v půdě a je přenosná osivem. V ČR výskyt tohoto patogena nebyl potvrzen.
Nádorovitost řepy
Nádorovitost řepy způsobuje bakterie Rhizobium radiobacter (známější pod starším názvem Agrobacterium tumefaciens). Bakterie má široký okruh hostitelů, napadá byliny i dřeviny. Choroba se na řepě objevuje zřídka, není hospodářsky významná.
Příznakem napadení je tvorba nádoru (tumoru) různé velikosti. Nádory se tvoří především na horní části bulvy. Mladé nádory jsou měkké, bílé až krémové barvy s hladkým povrchem, později jak nádory stárnou, tmavnou a dochází ke zvrásnění jejich povrchu. Nádory nejsou chráněné epidermis, jejich tkáň je houbovitá a rozpadá se.
Rhizobium radiobacter je gramnegativní, aerobní krátká tyčinka, pohyblivá 1–6 bičíky. Vytváří okrouhlé, hladké, světlé béžové kolonie. Optimální teplota pro růst bakterie je 25–28 °C. Infekci může způsobit jedna bakteriální buňka nesoucí plazmid Ti (Tumor Inducin). Začleněním plazmidu do genomu rostliny dochází k transformaci hostitelské buňky (nadprodukci cytokininů a auxinů, které jsou regulátory růstu rostlin) - ta se začne dělit, zvětšovat a vznikne nádor. Bakterie se do rostlinných pletiv dostávají přes poranění kořenů. Přežívají na okraji nádorů a v půdě, kde zůstávají až do dalšího vegetačního období. Šíří se deštěm a závlahovou vodou.
Ochrana
Ochrana proti bakteriálním chorobám spočívá v pěstování rezistentních odrůd a dodržování agrotechnických opatření, jako je střídání plodin, zapravení posklizňových zbytků, vysévání zdravého osiva a vyvážené výživy rostlin. Bakteriální choroby nezpůsobují významné škody, proto se přímá ochrana proti bakteriálním původcům neprovádí.

Kolonie bakterií rodu Pseudomonas

Rhizobium radiobacter - příznaky napadení (J. Smrž)

Rhizobium radiobacter - příznaky napadení (K. Jedličková)
Další články v kategorii Choroby

RSS
RSS RSS
RSS